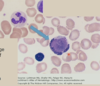

(1) Diseases of the Immune System I (Singh) Flashcards
(109 cards)
Innate Immunity
What is the general function?
What are the cells involved?
What are the proteins involved?
Pre-existing defense against pathogens
Cells: Neutrophils, Dendritic cells, NK cells
Proteins: Complement
Adaptive Immunity
General function?
What are the primary players?
Specific, programmed defense in response to antigen presence
LYMPHOCYTES (+antibodies)
Innate Immunity:
What are examples of physical barriers?
- Skin
- Lining of tracehal bronchial tree

Innate Immunity:
What are examples of chemical barriers?
- Saliva
- Tears
- Acidic pH of stomach

Innate Immunity
What are examples of pattern recognition receptors?
- Toll like receptors
- NOD-like receptors and the inflammasome
- C-type lectin receptors
What are the generative organs of the adaptive immune system?
Bone marrow
Thymus
What are the functions of the generative organs of the adaptive immune system?
-Bone marrow
-Thymus
Bone marrow
-Generation of lymphocyte stem cells
-B lymphocyte maturation
Thymus
- Maturation of T lymphocytes
What are the peripheral organs/tissues of adaptive immunity?
Lymph nodes
Spleen
Mucosa-associated lymphoid tissues [MALT] (tonsils, adenoids, peyer’s pathes)
What are the functions of the peripheral organs/tissues of the adaptive immune system?
Lymph nodes
Spleen
Mucosa-associated lymphoid tissues
Lymph nodes
-Lymphocytes can interact w/ APC’s and antigens in circulating lymph
Spleen
-Lymphocytes can interact with blood-borne antigens
Mucosa-associated lymphoid tissues
-Allow lymphocytes and plasma cells to be in the vicinity of antigens within the mouth and intestinal tract
Identify the structures at the arrows


Where do B cells mature?
Bone marrow
What organ is this?

Thymus
What is the overarching function of the thymus?
T Cell Training
Describe the maturation process of T cells
Cells that are destined to become T cells travel from the bone marrow to the thymus.
These cells start in the cortex, and as they mature, they travel inward toward the medulla (the center).

What is the goal of T cell maturation?
Not attack our own tissues
Teaching the T cells what our own MHC molecules look like, SO THEY DON”T ATTACK
What are the histologic features of the thymus?
Cortex
-TON of lymphocytes
Medulla
-Hassal corpuscles (squamous cell nests)

Describe the events that occur in the lymph node
APC’s interact with lymphocytes
- T and B cell clonal expansion
- B cell differentiation into plasma cells
- Migration of T cells and plasma cells out of lymph nodes and into circulation
T lymphocytes
Give the other name for the following:
Helper
Cytotoxic
Regulatory
Helper : CD4+
Cytotoxic : CD8+
Regulatory : Treg
General function of MHC?
Display peptides for T-cells in adaptive immunity
Describe MHC Class I
Where located?
What do they typically recognize?
How are they processed?
How are they expressed?
Which cells?
ALL nucleated cells (and platelets)
Recognize intracellular antigens (eg viral, tumor)
Processed into peptides by the proteasome
Peptides are transported to the ER, load into the groove of MHC, and the entire complex migrates to the surface
Presentation of complex to CD8+ (cytotoxic) T cells

Describe MHC Class II
Where located?
What do they typically recognize?
How are they processed?
How are they expressed?
Which cells?
Located on APCs
Recognize extracellular antigens (bacterial, allergens)
Processed into peptides by the endolysosomal enzymes
Vesicles form with processed peptides and MHC II complex
Present to CD4+ (Helper) T cells

What is the difference b/w MHC and HLA?
Human leukocyte antigens (HLA) are the Major histocompatibility complex molecules that are present in humans
Which chromosome encodes the HLA molecular structure for a given individual?
Chromosome 6
*Remember: there are 6 regions we care about.
- HLA-A
- HLA-C
- HLA-B
- HLA-DR
- HLA-DQ
- HLA-DP

How many HLA alleles are there?
1000’s